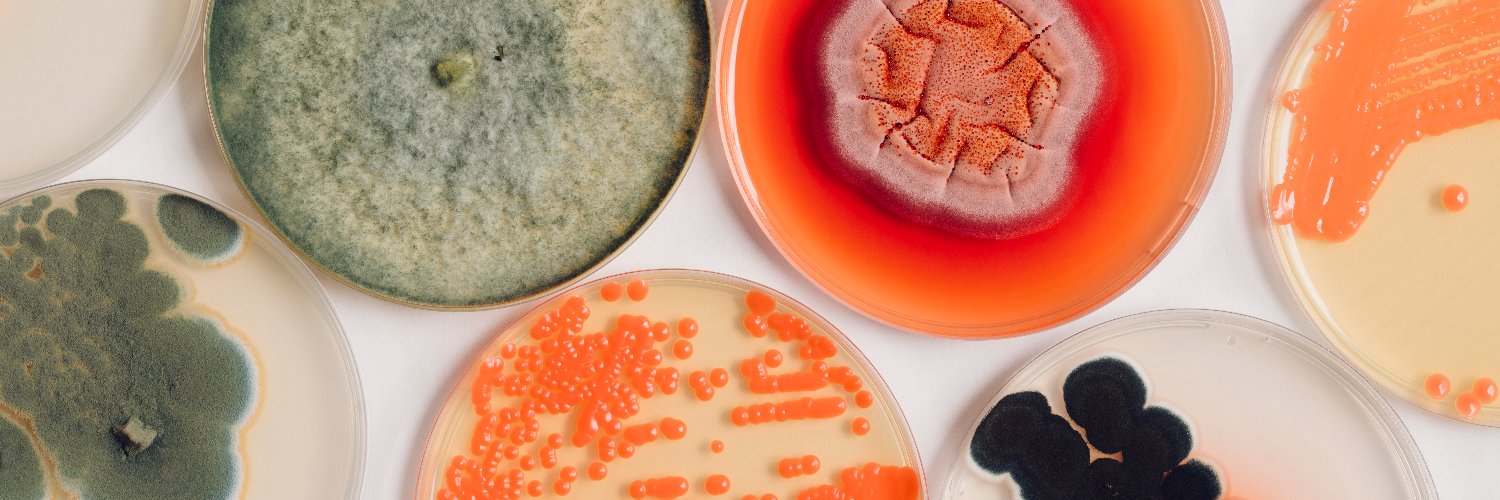
BioColour banner

The last chance to register for the BioColours2024 Conference taking place in Helsinki Finland June 3rd to 7th is TODAY! Check the bio for a link to the BioColours2024 Conference website or lyli.fi/BCregister.
#stn_akatemia
#universityofhelsinki
#biocolours2024

English